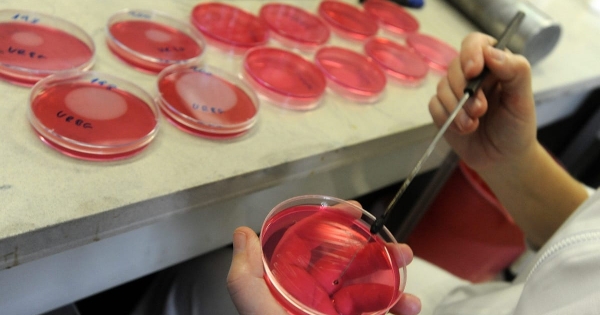
Rovarmaradvány volt az étcsokoládéban, visszahívták a forgalmazó meggyes és mandulás termékét is

Rovarmaradvány volt az étcsokoládéban, visszahívták a forgalmazó meggyes és mandulás termékét is
- 2025. szeptember 23.
Könyvelő hírfigyelő
- Hvg.hu
A Real Nature étcsokoládéjával kapcsolatban intézkedett a Nemzeti Kereskedelmi és Fogyasztóvédelmi Hatóság.

